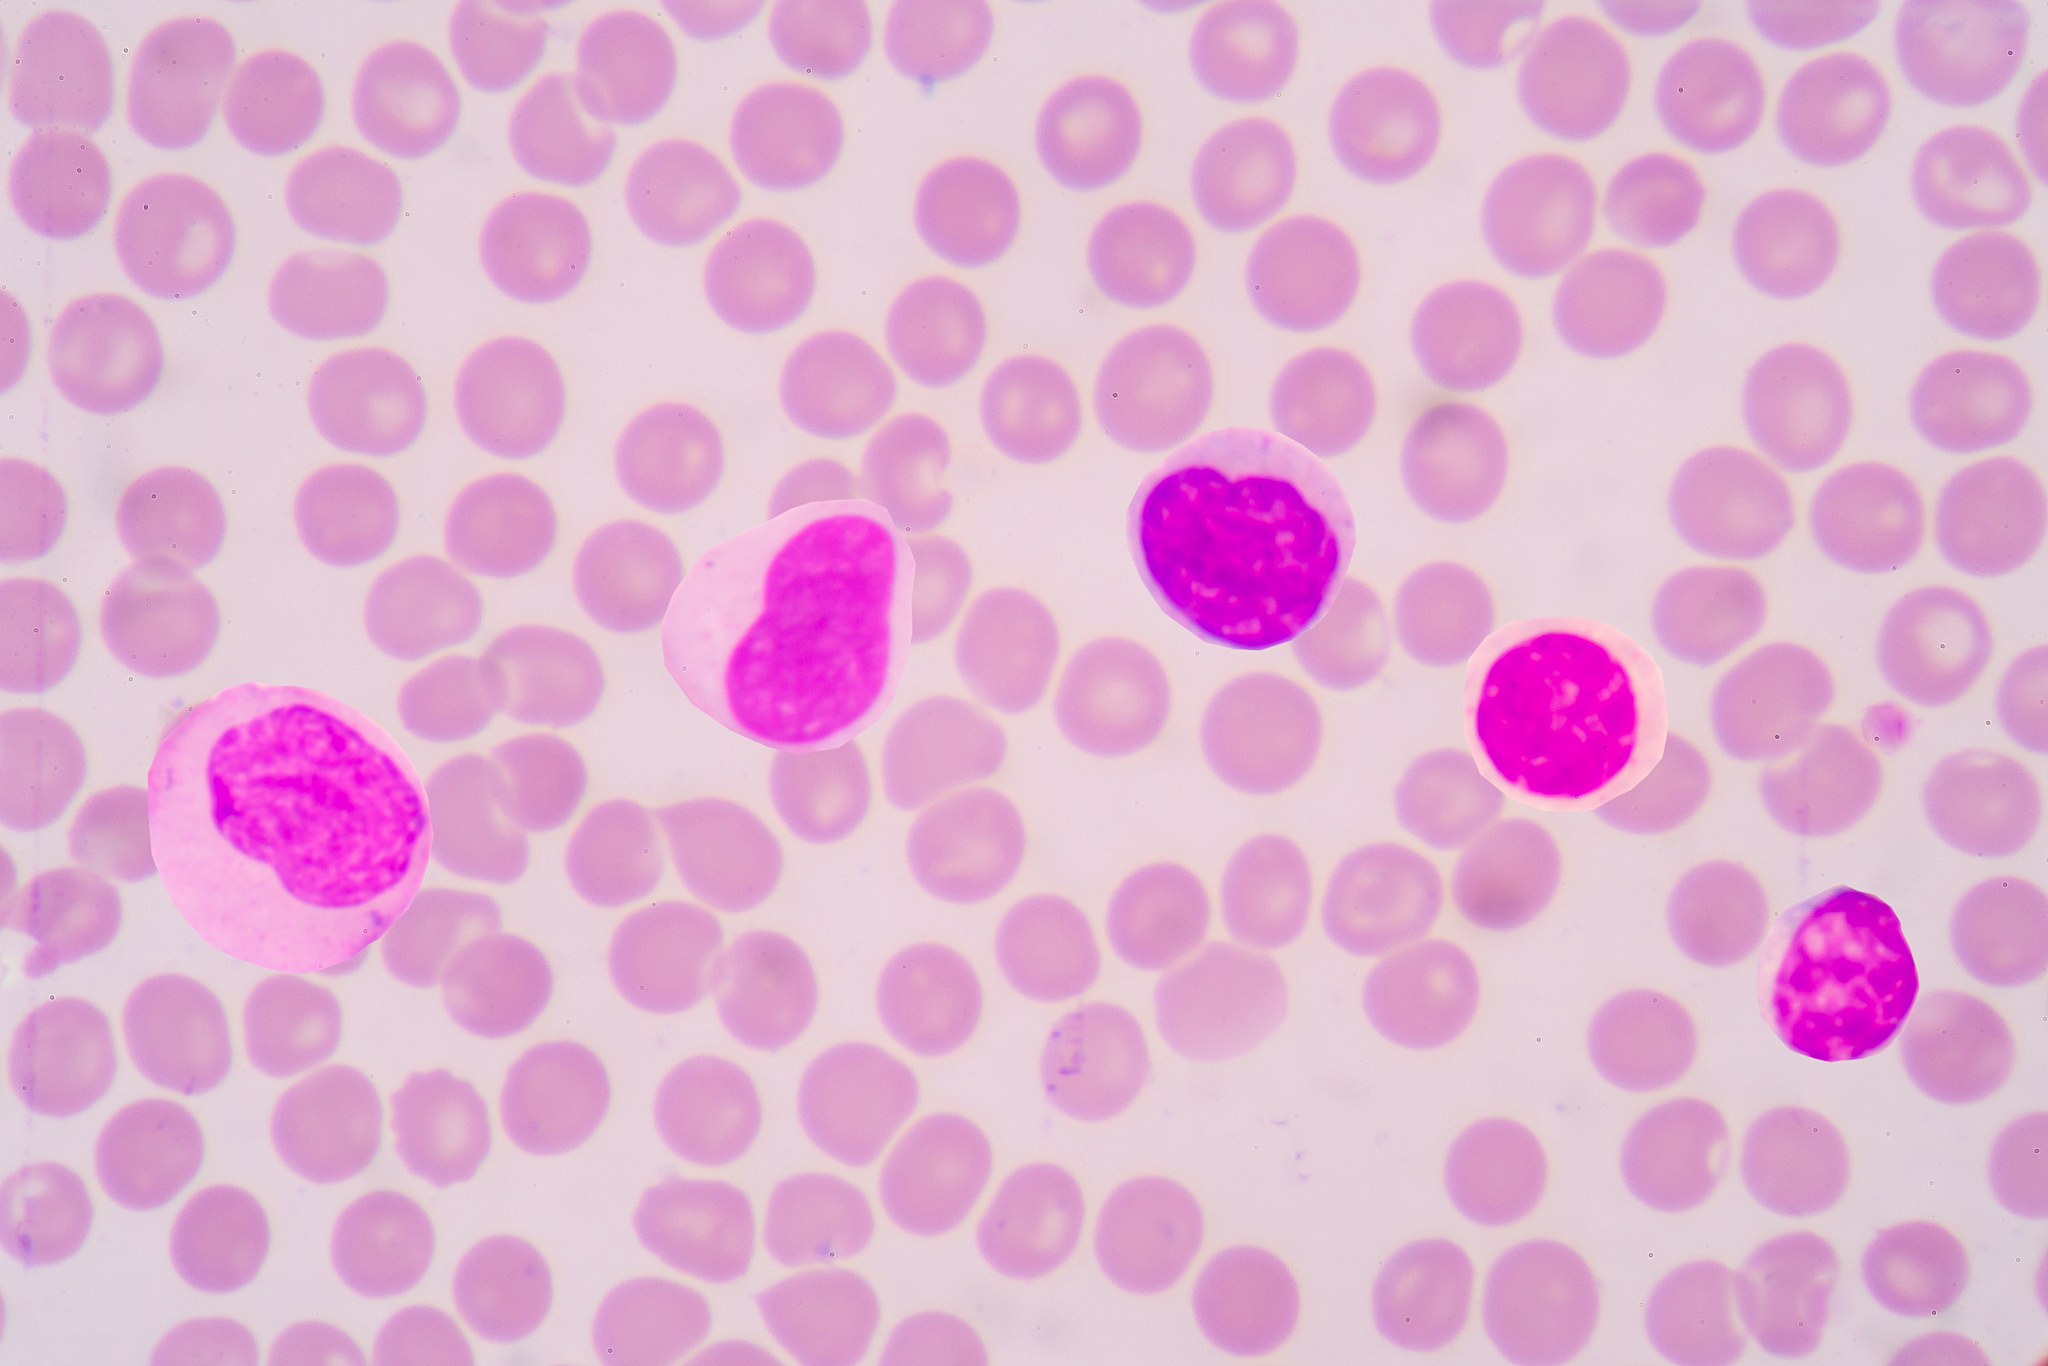
正常人体血液中白细胞比例:各类型占比差异及影响因素 正常人体血液中白细胞比例:各类型占比差异及影响因素

正常人体血液中白细胞比例:各类型占比差异及影响因素
正常人体血液中各白细胞组成比例并非相同,而是存在明显差异。正常情况下,血液中的白细胞主要包括中性粒细胞、淋巴细胞、单核细胞、嗜酸性粒细胞和嗜碱性粒细胞。它们的比例因个体差异、年龄、健康状况以及感染或疾病等因素而有所不同。一般来说,中性粒细胞在总白细胞中占比最高,约为50-70%,淋巴细胞次之,约为20-40%,单核细胞约为2-8%,嗜酸性粒细胞和嗜碱性粒细胞的比例较低,约为1-5%不等。
原文地址: https://www.cveoy.top/t/topic/qhe9 著作权归作者所有。请勿转载和采集!